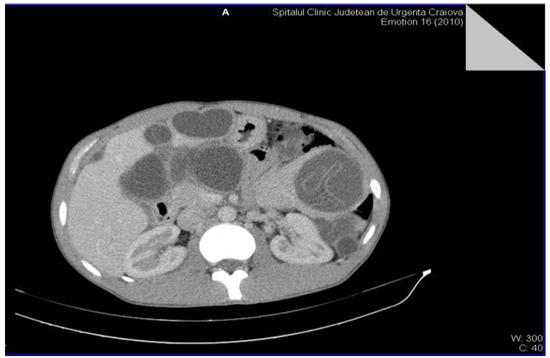

Abstract
Objectives. Hydatid disease is a potentially lethal parasitic condition caused by the larvae of Echinococcus Granulosus; it is found in humans and more commonly in domestic and wild animals in endemic areas. This pathology is frequently encountered in the liver, the hydatid cyst with retroperitoneal location representing a rarely encountered form of evolution. Materials and Methods. In the present paper, we present a study carried out on 6 patients hospitalized in the Surgery Department of the Craiova County Emergency Clinical Hospital. These patients were diagnosed between 2002–2022 with retroperitoneal hydatid cyst or with multiple cysts (including retroperitoneal), being operated and monitored postoperatively at a distance. Results. The diagnosis was generally established by clinical examination, laboratory investigations and CT imaging, while the MRI evaluation was performed only in two of the cases, in order to provide additional data necessary for the surgeon. Conclusions. The difficulty of surgical interventions was determined by the size and local/multilocular extension of the disease; in the case of one patient, a double approach, abdominal and thigh, was necessary.
Introduction
The hydatid cyst is usually caused by accidental human infection with the Taenia Echinococcus parasite. Taenia Echinococcus is a flatworm, found as an adult in the intestine of some carnivorous animals (dog, wolf, etc.), with a length of approximately 3–6 mm, being the smallest cestode in human parasitology [1]. It lacks a digestive tube, feeding on nutrients existing in the host’s intestine. The clinical evolution of the hydatid cyst is non-specific, depending on the number, size and location of the cysts.
In Romania, the incidence of this pathology is continuously increasing, accumulating 5–6 reported cases per 100,000 inhabitants yearly [2]. Generally, Echinococcus granulosus infection in humans occurs frequently in the liver (55–70%), followed by the lungs (18–35%), while two organs are affected simultaneously in approximately 5–13% of cases. The incidence in other organs is approximately 8–10% [3]. Although benign, this pathology, can lead to an increased level of morbidity and mortality. Hydatid cyst is most commonly seen in the liver and lungs, but retroperitoneal hydatid cyst is very rare [4,5]. The objective of this study is to evaluate the clinical and imaging data as well as the effectiveness of surgical treatment of this rare location.
Materials and Methods
We performed a retrospective study on 6 patients diagnosed with retroperitoneal hydatid cyst or with multiple localization (including retroperitoneal) between January 2002 and December 2022. They were admitted to the Surgery Department of the Craiova County Emergency Clinical Hospital to confirm the diagnosis and perform the surgical intervention. Because of this very rare pathology, all patients (over 18 years of age) from the mentioned period were included in the study. Two patients presented with multiple intra-abdominal sites, including the retroperitoneal area, so their management focused primarily on evaluation and treatment of retroperitoneal lesions. Being a study of a small number of patients, multiple data such as demographics, clinical and imaging investigations (CT, MRI), intraoperative surgical technique and post-operative results were analyzed.
Results
The patients included in the study were mostly men, aged between 20 and 50 years, with a peak in the 4th decade of age (4 patients) (Table 1), and most of the patients were from rural areas (4 patients) and had a unique location of the cyst in the retroperitoneal space. One patient presented an exceptional form of extension to another segment, namely at the level of the thigh through the muscular and vascular lacuna, while another patient presented other intraperitoneal cysts, including at the level of the mesorectum.

Table 1.
General data of the patients included in the study group.
Regarding the clinical symptomatology and form of presentation (Table 2), it was found that diffuse abdominal pain was frequently encountered, being the main reason for referral to the doctor even if the location was retroperitoneal. Only one patient was asymptomatic and 2 presented a palpable tumor formation: one at the level of the left flank and one at the level of the 1/3 superior part of the anterior side of the upper left thigh (Figure 1). Asthenia was found in 3 patients, but accompanied by other symptoms (diffuse abdominal pain or palpable tumor).

Table 2.
Clinical presentation and therapeutic management.

Figure 1.
Palpable tumor on the 1/3 superior part of the anterior side of the upper left thigh, immediately below the inguinal arch.
The definitive diagnosis of the retroperitoneal hydatid cyst was based on the anamnesis, clinical examination and paraclinical examinations, including serological examinations. The medical history of the patients was insignificant, but most of them were from rural areas and confirmed the close interaction with animals (sheep, goats, dogs). The clinical examination very rarely raises the suspicion of retroperitoneal hydatid cyst, the examinations of other systems and organs being normal. Most of the biological investigations were within normal limits. The serological examination by detecting the immunoglobulin G antibody by the ELISA method (enzyme-linked immunosorbent assay) was positive in all cases, showing high sensitivity and specificity and was only performed after raising the suspicion of hydatid cyst by imaging methods. Non-invasive imaging paraclinical investigations for the diagnosis of the disease were: abdominal (or regional) ultrasound, CT scan (computed tomography) and MRI (magnetic resonance imaging) that proved a high sensitivity. The presence of daughter cysts, hydatid sands, and floating membrane can confirm the diagnosis of hydatid cyst [6,7]. Abdominal ultrasound established the diagnosis in the case of 4 patients, and in the case of two patients it raised the suspicion of retroperitoneal hydatid cyst. The CT examination was carried out in 5 patients, for diagnostic purposes or for the remote evaluation of the lesions. In 2 patients, the tomographic diagnosis was accidental, without clinical or paraclinical suspicion of abdominal hydatid cysts and revealed their single or multiple presence, either only retroperitoneally or also intraperitoneally (Figure 2 and Figure 3).
Figure 2.
Multiple intra-abdominal hydatid cysts.

Figure 3.
Intra-abdominal hydatid cysts.
The MRI examination was performed on two patients for surgical purposes, to establish the relationship with other organs or vital structures and to guide the indication and the surgical plan. It is important to note the case of a 32-year-old male patient, hospitalized for the presence of a tumor formation at the base of the left thigh, in which the native and contrast enhanced MRI examination of the pelvis and thigh revealed: urinary bladder without parietal thickenings or endoluminal pathological processes; seminal vesicles without pathological signal changes; prostate measuring 4.7/3.2 cm, homogeneous, without pathological contrast plugs; without suspicious adenomegaly at the pelvic level; replacement process of polylobate space, which is relatively well demarcated, predominantly with fluid signal, multiple septate, without diffusion restriction, with gadophilia present at the peripheral and intralesional septal level, starting from the vicinity of the psoas and iliac muscle on the left side and extending into caudal direction through the anterior portion of the inguinofemoral region on the left side to the proximal region of the left thigh, and coming into contact with the common iliac, external iliac and femoral vessels on the left side (apparently with preserved flow at their level and with the apparently left femoral diaphysis but no macroscopic invasion phenomena at this level); previously described space-replacing process, which extends over a cranio-caudal distance of approximately 33 cm and shows inhomogeneous signal at the level of some of the intralesional cystic areas; deep to the gluteus maximus muscle on the left side, a relatively well-defined area can be seen, with a polylobate contour, multiple septa, with a similar appearance to the previously described space-replacing process, with dimensions of 2.9/2.75 cm—possibly parasitic cystic lesions (Figure 4, Figure 5, Figure 6, Figure 7, Figure 8 and Figure 9).

Figure 4.
STIR MRI sequence, coronal—Hydatid cyst with daughter cells present in the left thigh.

Figure 5.
T2W MRI sequences, coronal—Hydatid cyst of left iliopsoas muscle and left thigh, with daughter cells and Serpent sign present [8] (part 1).

Figure 6.
T2W MRI sequences, coronal—Hydatid cyst of left iliopsoas muscle and left thigh, with daughter cells and Serpent sign present [8] (part 2).

Figure 7.
T2W MRI sequence, sagittal—Hydatid cyst left iliopsoas muscle and left thigh (part 1).

Figure 8.
T2W MRI sequence, sagittal—Hydatid cyst left iliopsoas muscle and left thigh (part 2).

Figure 9.
Axial T1W +C MRI sequence—hydatid cyst with peripheral and septal gadolinophilia.
As far as the surgical intervention is concerned, the surgical plan was decided and established after the diagnosis was defined, the specific drug therapy being with albendazole. The objectives of the surgical intervention were the complete and total excision of the cysts (in cases of multiple localization) or, when the ideal cystectomy can be performed: the inactivation of the parasite, the evacuation of the cyst cavity, the elimination of the germinal membrane and the prevention of the intra-operative dissemination of parasites. Complete and total radical cystectomy (in cases with multiple localization) was performed in 4 patients, and pericystectomy and drainage of remaining cavities in 2 patients. All surgical interventions were performed through median laparotomy under orotracheal intubation (Figure 10 and Figure 11).

Figure 10.
Appearance after resection of retroperitoneal hydatid cyst.

Figure 11.
Operative parts: multiple intra-abdominal cysts (intra and retroperitoneal).
In general, the total excision of the pericyst is ideal, but in these 2 cases, due to the relationship with the vital structures and the development in two anatomical segments as well as the communication through the vascular and muscular lacuna, this procedure was impossible. We believe it is important to present the approach of this exceptional placement. The first time of the intervention was the isolation of the sloping portion at the level of the thigh for the purpose of efficient drainage (Figure 12).

Figure 12.
Highlighting the cyst in the thigh.
The abdominal approach was performed through median pubosupraumbilical laparotomy (Figure 13). The left paramedian retroperitoneum was exposed by taking off the sigmoid colon and isolating the spermatic pedicle and the left ureter. The intraoperative evaluation of the lesion reveals: a polylobate tumor formation that occupies the left paramedian retroperitoneum, below the bifurcation of the renal artery and passes under the inguinal arch through the muscular and vascular gap at the level of the hip. The dissection of the tissue pericyst is very difficult, and when the cyst is opened, after isolating the peritoneal cavity, multiple germinal membranes and a large amount of clear liquid are discharged. The opening of the cyst in the sloping portion (from the level of the pelvis) ensured the evacuation of germinal membranes and small vesicles after performing an effective lavage through the upper pole of the cyst (located intraabdominally) (Figure 14, Figure 15 and Figure 16). The digital exploration of the outstanding cavity finds the retroperitoneal mutisaccular development, the communication through the muscular and vascular lacuna with a similar cavity located at the base of the left thigh.

Figure 13.
Double approach: abdominal and at the level of the left thigh

Figure 14.
Evacuated germinal membranes after opening the cyst.

Figure 15.
Partial dissection of the pericyst, after evacuation, from the thigh.

Figure 16.
Intraoperative aspect: retroperitoneal drainage of the remaining cavity through the muscular lacuna.
Considering the impossibility of performing an ideal cystectomy, it was decided to perform an efficient drainage by closing the remaining retroperitoneal cavity after mounting a drain tube (through which the lavage and drainage slope at the base of the left thigh with tubes passed through the muscle gap is carried out). Adjacent peritoneal drainage and anatomical parietorrhaphy. Native MRI examination and post-operative intravenous post-contrast (Figure 17 and Figure 18), reveals: diffuse infiltrative-edematous appearance at the level of the iliopsoas muscle on the left side, with the presence of a collection with peripheral type gadophilia, difficult to appreciate under dimensional ratio, with a tendency to diffuse extension, developed predominantly intramuscularly at the level of the psoas muscle on the left side, with the predominant interest of its peripheral portion between 7–3 o’clock (being tangent to the external iliac vessels on the left side, with present, homogeneous flow at their level), extended to at the level of the ipsilateral iliac muscle and later in a caudal direction at the level of the iliopsoas muscle on the left side up to the vicinity of its distal insertion, after which it insinuates between the muscles of the antero-internal region of the thigh on the left side up to the border between the proximal third and the middle third of the thigh, and coming into contact on several sections with the femoral vessels on the left side, but without causing changes in caliber or flow at their level. At the level of the proximal portion there is a fistulous tract with a maximum thickness of approximately 0.7 cm, externalized at the level of the root of the left thigh in the antero-internal region which seems to communicate in depth with the previously described collection. In the proximal portion of the thigh on the left side, diffuse infiltrative-edematous changes adjacent to the previously described collection are evident at the level of the intermuscular space in the anterior region of the thigh, without being accompanied by similar changes at the level of the muscles in the anterior region of the thigh (Figure 17 and Figure 18).

Figure 17.
T2W sequence, sagittal—Postoperative residual hydatid cyst located at the level of the left iliopsoas muscle and deep to the left gluteus maximus muscle (part 1).

Figure 18.
T2W sequence, sagittal—Postoperative residual hydatid cyst located at the level of the left iliopsoas muscle and deep to the left gluteus maximus muscle (part 2).
Deep from the gluteus maximus muscle on the left side, there are multiloculated, multiple septate intralesional, relatively well delimited areas, which seem to communicate both with each other and with lesions of a similar appearance located in the thickness and adjacent to the quadratus femoris muscle on the left side, with total dimensions in the coronal plane of approximately 11.3/6.4 cm, with the most likely appearance of parasitic cysts (Figure 19, Figure 20 and Figure 21).

Figure 19.
T2W sequence, axial—Postoperative residual hydatid cyst located at the level of the left psoas muscle and deep to the left gluteus maximus muscle (part 1).

Figure 20.
T2W sequence, axial—Postoperative residual hydatid cyst located at the level of the left psoas muscle and deep to the left gluteus maximus muscle (part 1).

Figure 21.
T1W +C MRI sequence, coronal—Outstanding hydatid cyst with daughter cells present, located deep to the gluteus maximus muscle on the left side, with peripheral gadolinophilia.
Discussions
The adult form of the parasite Echinococcus Granulosus lives in the dog’s small intestine, which is the definitive host. In some countries, wild animals (hyena, fox, wolf) harbor the parasite. The larval form of the parasite has no specific host, it can be found in several mammals: sheep, goats, cattle, pigs, etc. The actual hydatid tumor consists of two distinct parts, the cyst wall and the cyst content. The positive diagnosis of the retroperitoneal hydatid cyst is established by corroborating the data brought by the anamnesis, the objective examination and the paraclinical examinations. In the case of localizations inaccessible to classic radiology or ultrasonography, when the diagnosis by the mentioned methods is uncertain or surgical treatment is considered, imaging by MRI or computed tomography is indicated [9]. On computed tomographic examination, hydatid cystic lesions are visualized as well-demarcated areas with internal fluid densities, with frequent focal areas of calcification, located peripherally, which usually signifies the absence of active infection (if it is circumferentially). Septa and daughter cells can also be visualized.
The appearance of the water lily flower, or water lily sign, indicates the detachment of the endocyst. Intracystic fluid may show variable attenuation depending on the amount of protein debris present. Magnetic resonance imaging gives us the opportunity to visualize cystic lesions, as well-defined, inhomogeneous areas in hyposignal T1 (dependent on the amount of cellular protein debris), hypersignal T2 and STIR, with or without the presence of septa or daughter cells inside, showing peripheral gadolinophilia [5,6,7,8].
The clinical evolution of the hydatid cyst is non-specific, depending on the number, size and location of the cyst, therefore most of the time the diagnosis is made late [10,11]. The natural evolution of the hydatid cyst is slow, the development of the cyst taking place over several years, with a variable growth rate in diameter of approximately 1–1.5 cm per year. Surgical intervention is the best therapeutic method in favor of healing, while drug therapy has an adjuvant role. In our study, radical cystectomy was ideal, especially if it is a multiloculated intra-abdominal form (both retroperitoneal and intraperitoneal), but there are situations in which this cannot be done, and the alternative is pericystectomy and effective drainage of the remaining cavity [4,12]. In the case of the fused retroperitoneal cyst at the base of the thigh, the diagnosis is difficult to establish, the MRI examination bringing the most information. The surgical intervention was difficult and the incomplete evacuation of all the spaces occupied by the cyst was not possible, in this way the relapse occurred, and in such cases drug treatment is necessary until a new surgical intervention. The medical treatment of hydatid cyst, totally ineffective in the past, made great progress with the discovery of benzimidazole derivatives, known as Albendazole and Mebendazole.
Both drugs can reduce the size of hydatid cysts and in some cases can even lead to sterilization of the contents of the hydatid cyst. These drugs interfere with glucose uptake mechanisms through the parasite wall that result in glycogen depletion and subsequent degenerative changes in the mitochondria and endoplasmic reticulum of germ cells. The parasite dies and the germinal membrane undergoes a process of vesiculation and fibrosis, becoming infertile. Albendazole is more active in vitro than mebendazole, has better bioavailability and gastrointestinal absorption, and has better clinical outcomes. The intracystic level of Albendazole is 48–156% compared to its plasma level [13,14,15]. The differential diagnosis in such cases poses particular problems, being done with tumors of the left colon, rectum [16,17], lipomatous tumors fused at the base of the thigh [18,19] or kidney cysts [20,21,22]. In the specialized literature, the cases of retroperitoneal hydatid cysts are very rare. Therefore, we presented a special case in which the retroperitoneal hydatid cyst has evolved at the base of the thigh through the muscular and vascular lacuna.
Conclusions
The retroperitoneal hydatid cyst can take multiple clinical forms, and the lack of adequate medical and surgical treatment can lead to variable forms of evolution. The retroperitoneal hydatid cyst can be unique or localized to other extrahepatic organs, and the clinical form of fusion at the base of the thigh through the muscular and vascular lacuna is totally exceptional.
Author Contributions
Popa Dragoș-George, Ahmet Rukie Ana-Maria and Florescu Lucian have contributed equally to this paper.
Informed Consent Statement
Any aspect of the work covered in this manuscript has been conducted with the ethical approval of all relevant bodies and that such approvals are acknowledged within the manuscript. Informed consent was obtained from all subjects involved in the study.
Conflicts of Interest
There are no known conflicts of interest in the publication of this article. The manuscript was read and approved by all authors.
References
- McManus, D.P.; Zhang, W.; Li, J.; Bartley, P.B. Echinococcosis. Lancet 2003, 362, 1295–1304. [Google Scholar] [CrossRef] [PubMed]
- Botezatu, C.; Mastalier, B.; Patrascu, T.; Hospital, G.S.C. Hepatic hydatid cyst—Diagnose and treatment algorithm. J. Med. Life 2018, 11, 203–209. [Google Scholar] [CrossRef]
- Goyal, S.; Sangwan, S.; Sachar, S. Uncommon locations and presentations of hydatid cyst. Ann. Med. Health Sci. Res. 2014, 4, 447–452. [Google Scholar] [CrossRef] [PubMed]
- Aydinli, B.; Ozturk, G.; Polat, K.Y.; Atamanalp, S.S.; Ozbey, I.; Onbas, O.; Akcay, M.N.; Balik, A.A.; Guvendi, B. Extravisceral primary hydatid cyst of The retroperitoneum. ANZ J. Surg. 2007, 77, 455–459. [Google Scholar] [CrossRef]
- Pedrosa, I.; Saíz, A.; Arrazola, J.; Ferreirós, J.; Pedrosa, C.S. Hydatid Disease: Radiologic and Pathologic Features and Complications. RadioGraphics 2000, 20, 795–817. [Google Scholar] [CrossRef]
- Mehri, A.; Mehri, A.; Esparham, A.; Esparham, A.; Rezaei, R.; Rezaei, R. Primary retroperitoneal hydatid cyst, a rare novel differential diagnosis of retroperitoneal masses: A case report. Clin. Case Rep. 2022, 10, e6615. [Google Scholar] [CrossRef]
- Xiang, H.; Han, J.; E Ridley, W.; Ridley, L.J. Snake or serpent sign: Hydatid. J. Med. Imaging Radiat. Oncol. 2018, 62, 107. [Google Scholar] [CrossRef] [PubMed]
- Abbasi, B.; Akhavan, R.; Khameneh, A.G.; Amirkhiz, G.D.H.; Rezaei-Dalouei, H.; Tayebi, S.; Hashemi, J.; Aminizadeh, B.; Amirkhiz, S.D.H. Computed tomography and magnetic resonance imaging of hydatid disease: A pictorial review of uncommon imaging presentations. Heliyon 2021, 7, e07086. [Google Scholar] [CrossRef]
- Gavriilidis, P.; Ananiadis, A.; Theodoulidis, V.; Barbanis, S. Primary retroperitoneal echinococcal cyst. BMJ Case Rep. 2012, 2012, bcr2012006465. [Google Scholar] [CrossRef]
- Angulo, J.C.; Escribano, J.; Diego, A.; Sanchez-Chapado, M. Isolated retrovesical and extrarenal retroperitoneal hydatidosis: clinical study of 10 cases and literature review. J. Urol. 1998, 159, 76–82. [Google Scholar] [CrossRef]
- Yang, G.; Wang, X.; Mao, Y.; Liu, W. Case report of primary retroperitoneal hydatid cyst. Parasitol. Int. 2011, 60, 333–334. [Google Scholar] [CrossRef] [PubMed]
- Creţu, C.M.; Codreanu, R.R.; Mastalier, B.; Popa, L.G.; Cordoş, I.; Beuran, M.; Ianulle, D.A.S.; Simion, S. Albendazole associated to surgery or minimally invasive procedures for hydatid disease—How much and how long. Chirurgia 2012, 107, 15–21. [Google Scholar]
- Infanger, M.; Kossmehl, P.; Grimm, D. Surgical and medical management of rare echinococcosis of the extremities: Pre- and post-operative long-term chemotherapy. Scand. J. Infect. Dis. 2005, 37, 954–957. [Google Scholar] [CrossRef] [PubMed]
- Diaconescu, M.; Obleaga, C.; Mirea, C.; Ciorbagiu, M.; Moraru, E.; Vilcea, I. Mandatory multidisciplinary approach for the evaluation of the lymph node status in rectal cancer. J. Mind Med. Sci. 2018, 5, 29–38. [Google Scholar] [CrossRef]
- Zendeoui, A.; Gharbi, M.A.; Nefiss, M.; Ezzine, M.H.; Tborbi, A.; Bouzidi, R. Primary extrahepatic hydatid cyst of the thigh, an unusual presentation of sciatica: A case report of a diagnostic challenge. Int. J. Surg. Case Rep. 2024, 117, 109545. [Google Scholar] [CrossRef]
- Vîlcea, I.D.; Victor, R.; Mirea, C.S.; Simionescu, C.E.; Mogoantă, S.Ş.; Moraru, E.; Vasile, I.M.; Ciorbagiu, M.C.; Obleagă, C.V.; Crafciuc, A.V.; et al. Extrarenal retroperitoneal angiomyolipoma with unusual evolution. Rom. J. Morphol. Embryol. 2015, 56, 263–266. [Google Scholar]
- Kafadar, M. Primary hydatid cyst of the left-sided colon presenting with lower gastrointestinal bleeding; an extremely rare location of extrahepatic hydatid disease. Niger. J. Clin. Pr. 2021, 24, 1569–1571. [Google Scholar] [CrossRef]
- Ammar, A.; Riahi, H.; Chaabouni, M.; Venturelli, N.; Renault, V.; Dray, B.; Safa, D.; Abid, L.; Bouaziz, M.C.; Carlier, R.-Y. The multifaceted musculoskeletal hydatid disease. Skelet. Radiol. 2024, 53, 2181–2194. [Google Scholar] [CrossRef]
- Mateescu, M.-C.; Grigorescu, S.; Socea, B.; Bloanca, V.; Grigorescu, O.-D. Contribution to the Personalized Management of the Nosocomial Infections: A New Paradigm Regarding the Influence of the Community Microbial Environment on the Incidence of the Healthcare-Associated Infections (HAI) in Emergency Hospital Surgical Departments. J. Pers. Med. 2023, 13, 210. [Google Scholar] [CrossRef]
- Iorga, L.; Anghel, R.; Marcu, D.; Socea, B.; Diaconu, C.; Bratu, O.; Andronache, L.; Paunica, S.; Mischianu, D. Primary renal hydatid cyst—A review. J. Mind Med. Sci. 2019, 6, 47–51. [Google Scholar] [CrossRef]
- Darani, H.Y.; Jafari, R. Renal echinococcosis; the parasite, host immune response, diagnosis and management. J. Infect. Dev. Ctries. 2020, 14, 420–427. [Google Scholar] [CrossRef]
- Salamone, G. Uncommon localizations of hydatid cyst. Review of the literature. G Chir. 2016, 37, 180–185. [Google Scholar] [CrossRef] [PubMed]
© 2024 by the author. 2024 Dragoș George Popa, Cosmin Vasile Obleagă, Ana Maria Rukie Ahmet, Cristin Constantin Vere, Vlad Ionuț Ducu, Cecil Sorin Mirea, Dan Nicolae Florescu, Mihai Călin Ciorbagiu, Dragoş Marian Popescu, Costin Teodor Streba, Lucian Florescu, Teodor Sas, Lorena Sas

